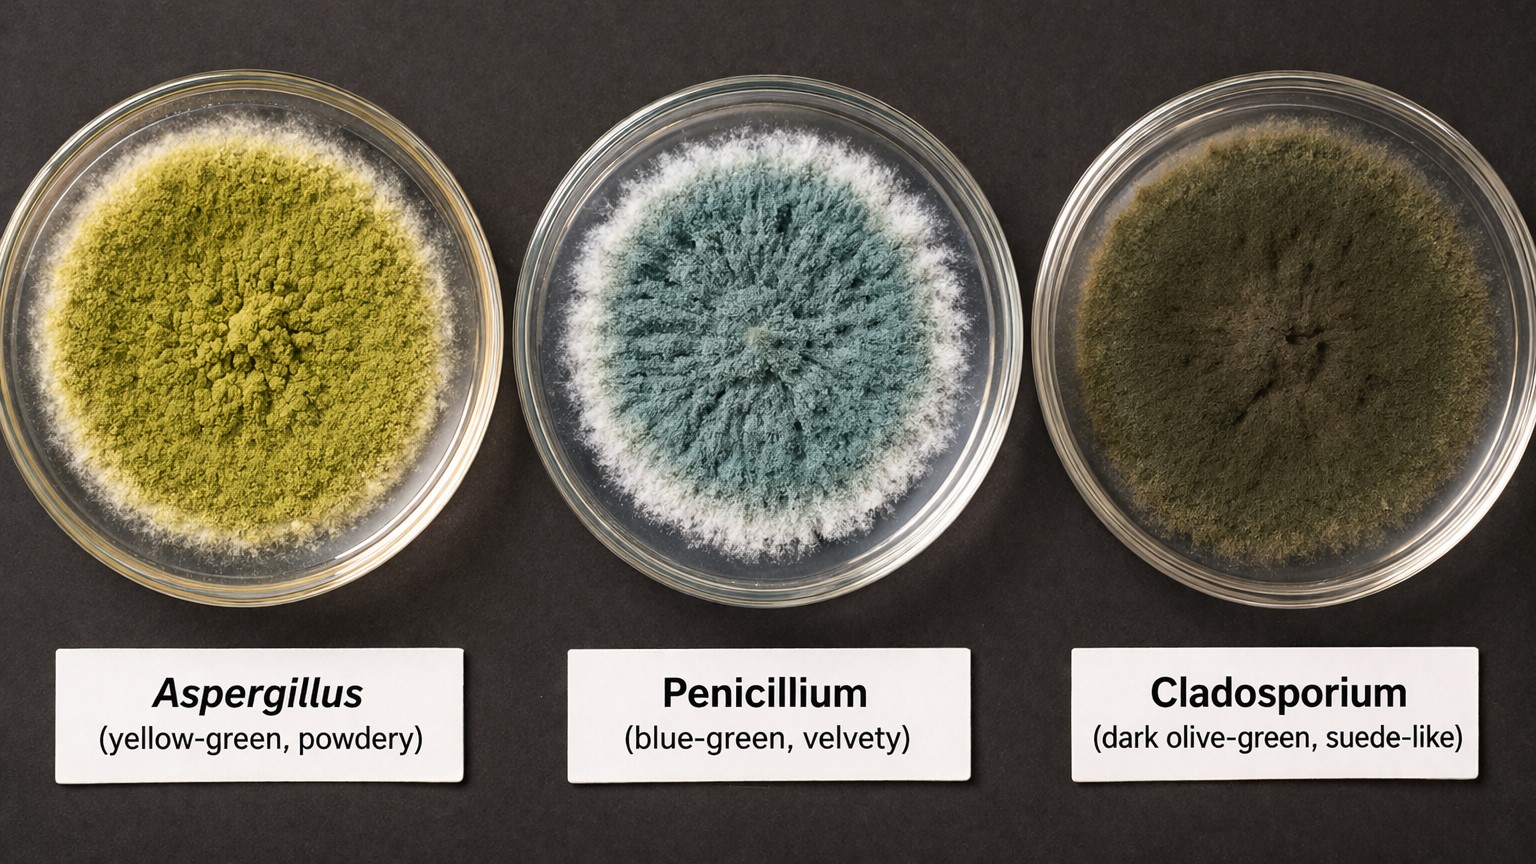
Aspergillus Penicillium and Cladosporium green mold species comparison

Green mold is a fungal growth caused most often by Aspergillus, Penicillium, or Cladosporium — all capable of triggering respiratory symptoms, allergic reactions, and structural damage. It is not automatically less dangerous than black mold. If you've spotted green patches on a wall, in your basement, or on wood after water damage, here's exactly what you're dealing with and what to do next.
Quick Answer
- Green mold is most commonly Aspergillus, Penicillium, or Cladosporium — three distinct species with different risk levels
- It appears as fuzzy, velvety, or powdery patches ranging from pale mint to dark olive green
- Yes, it can make you sick — respiratory irritation, skin rash, fatigue, and in some cases mycotoxin exposure
- It is not automatically safer than black mold — Aspergillus and Penicillium both produce mycotoxins in certain conditions
- Areas smaller than 10 sq ft on non-porous surfaces can be handled DIY; anything larger, recurring, or on porous material needs a professional
- The moisture source must be fixed — mold always returns if the underlying humidity problem isn't resolved
What Does Green Mold Look Like?
Green mold appears as fuzzy or powdery patches ranging from pale mint to dark olive green, often accompanied by a musty, earthy smell that's strongest in enclosed spaces like closets, crawl spaces, and poorly ventilated bathrooms.
It typically starts as a cluster of small spots — easy to miss on grout, wood grain, or in corner shadows. Within days, those spots expand into a visible colony. The texture tells you something useful: fuzzy or velvety growth points toward Aspergillus or Penicillium, while a dry, powdery appearance suggests Cladosporium.
| Feature | What You Typically See |
|---|---|
| Color range | Pale mint → bright green → olive → dark green-black |
| Texture | Fuzzy or velvety (Aspergillus, Penicillium) / powdery (Cladosporium) |
| Surface feel | Raised and soft — not flat like mildew |
| Smell | Musty, earthy — more intense in enclosed areas |
| Growth pattern | Small spots that expand outward quickly in humid conditions |
Color alone won't identify the species. That requires lab testing. But the visual pattern gives you a starting point for deciding how to respond.

H3: Green Mold vs. Mildew — 30-Second Test
Here's where a lot of homeowners get confused. Mildew is white or gray, flat, powdery, and stays on the surface — wipe it with a damp cloth and it's gone. Green mold is different in a way that matters: it penetrates the material it grows on.
The test: Wipe the growth with a damp cloth. Check back in 3–5 days.
- Comes back in the same spot → mold — it has rooted into the surface
- Stays clean → mildew — surface contamination, easier to address
If you're dealing with mold, surface wiping won't resolve it. The material either needs deep treatment or physical removal, depending on what it's made of.
Is Green Mold Dangerous?
Yes — all green mold species can cause health problems. The severity depends on the species, how long exposure has been occurring, the size of the colony, and the health status of the people in the home.
That last factor matters more than most people realize. Someone in good health may notice only mild allergy symptoms. Someone with asthma, COPD, or a compromised immune system living in the same house could develop a serious respiratory condition from the same mold colony.
Symptoms of Green Mold Exposure
Symptoms typically begin with the respiratory and immune system and worsen with prolonged exposure:
- Persistent coughing, wheezing, or shortness of breath
- Nasal congestion, runny nose, sneezing
- Watery, red, or irritated eyes
- Skin rash or hives
- Chronic fatigue and headaches
- In extended exposure: hypersensitivity pneumonitis, chronic bronchitis
- With mycotoxin-producing species (Aspergillus, Penicillium): research suggests potential kidney and liver stress at high exposure levels — though this remains an area of ongoing study
The tricky part is that many of these symptoms mirror seasonal allergies or a mild cold. If symptoms appear at home and ease when you're away, mold exposure is a reasonable explanation worth investigating.
For a more detailed breakdown of the health mechanisms involved, see our guide on the health risks of mold exposure and why it must be removed.

Who Is Most at Risk?
The CDC and EPA both identify specific groups for whom mold exposure carries greater clinical risk:
- Children under 5 — developing immune and respiratory systems
- Adults 65 and older — particularly those with existing COPD or cardiac conditions
- Asthma and allergy sufferers — mold is a primary indoor asthma trigger
- Pregnant women — mycotoxin exposure during pregnancy carries documented developmental risk
- Immunocompromised individuals — chemotherapy patients, transplant recipients, those on immunosuppressants; Aspergillus in particular can cause invasive pulmonary aspergillosis, a potentially life-threatening infection
If any of these apply to someone in your household and you've found green mold, don't wait to see whether symptoms develop. Call (877) 360-5502 for a same-day professional inspection.
Types of Green Mold — What Matters for You
Not all green molds carry the same risk, grow in the same places, or respond to the same removal methods. You can't identify species by eye — that requires air sampling or surface testing. But knowing the most common types helps you understand what you're likely dealing with based on where the mold is growing and what it looks like.
| Species | Appearance | Typically Found | Risk Level | Recommended Action |
|---|---|---|---|---|
| Aspergillus | Yellow-green, powdery | Walls, HVAC ducts, plant soil | High — some strains produce aflatoxins | Professional if > 10 sq ft or in HVAC |
| Penicillium | Blue-green, velvety | Food, damp wood, drywall | Medium-High — type 1 allergen, ochratoxin A | DIY small visible areas / Pro for large or hidden |
| Cladosporium | Olive to dark green, suede-like | Fabrics, carpet, wood surfaces | Medium — strong allergen, lower toxicity | Remove affected materials, fix moisture |
| Trichoderma | White-green patches | Wood, soil, compost | Low-Medium | Fix moisture source, treat surface |
| Fusarium | Pale green to white | Plants, damp building materials | Low-Medium | Remove and dry |
And here's something worth knowing: Cladosporium is often mistaken for black mold because it can appear nearly dark green to black in certain lighting. If you're unsure, don't guess — lab testing is the only reliable way to confirm species.
Aspergillus deserves specific attention for HVAC systems. When it colonizes ductwork, spores circulate throughout the entire home with every heating or cooling cycle. What looks like a small visible patch near a vent may indicate a much larger colony inside the system.
Green Mold vs. Black Mold
Black mold (Stachybotrys chartarum) produces trichothecene mycotoxins — among the most potent produced by any indoor mold species. But green mold should not be dismissed simply because it isn't black.
Aspergillus, one of the most common green molds, produces aflatoxins — classified as Group 1 carcinogens by the International Agency for Research on Cancer at high exposure levels. Penicillium produces ochratoxin A, linked in research to kidney damage. The difference in toxicity between green and black mold is real, but smaller than most homeowners assume.
The practical distinction:
Stachybotrys only grows on materials that have been chronically wet — think drywall or wood that has been saturated for weeks or months. If you have black mold, it almost always signals a serious, long-standing moisture problem. Green molds appear in a wider range of conditions and at lower sustained moisture levels, which is actually why they're more commonly found in homes.
Color does not determine safety. The only thing that determines safety is identification through testing, followed by proper removal.
If you're dealing with dark-colored mold and aren't sure which species you have, our guides on black mold on drywall and whether it's safe to clean black mold yourself cover the full picture.
Where Green Mold Grows in Your Home
Green mold appears wherever moisture meets an organic surface — and in most homes, there are more of those combinations than people expect.
- Bathroom — grout lines, caulk around the tub, ceiling corners above the shower. The humidity spike after every shower creates near-ideal conditions. Poor exhaust ventilation turns a bathroom into a mold incubator within weeks.
- Basement — floor joists, exposed concrete block, drywall on below-grade walls. Ground moisture migrates upward constantly in unfinished or poorly sealed basements. Cladosporium thrives here even at cooler temperatures.
- Walls — green mold on an interior wall surface usually signals something behind it: a slow plumbing leak, exterior water infiltration, or condensation forming inside the wall cavity. The visible mold is the symptom; the moisture problem is the cause.
- Wood — framing, subfloor sheathing, wood furniture, floor joists. Wood is an ideal cellulose substrate for Penicillium and Aspergillus. After any water damage, wood that isn't dried to below 19% moisture content within 48 hours is at serious colonization risk.
- Food — bread, soft cheeses, fruit, and leftovers. Penicillium moves fast on food. The FDA advises discarding moldy soft foods entirely — the mycelium extends well beyond the visible surface, and cutting around the mold doesn't remove the contamination.
- Clothes and fabrics — stored damp, kept in a humid closet, or left in a washing machine too long. Wash in the hottest water safe for the fabric; for heavily affected items, replacement may be more practical than remediation.
For a closer look at what happens when mold goes undetected in walls and building materials, see our piece on Chaetomium mold and hidden structural growth.
How to Get Rid of Green Mold (Step-by-Step)
You can DIY green mold removal if the affected area is smaller than 10 square feet, the mold is on a non-porous surface, and there's no evidence of hidden moisture behind walls or under floors. Anything beyond those parameters belongs with a professional — attempting DIY on larger or deeper infestations typically spreads spores and makes the problem worse.
Before you start: Open a window in the room for ventilation. Close doors to other parts of the house. Turn off any HVAC that circulates air through the space.

Step 1: Gear up N95 respirator mask (not a basic dust mask), nitrile or rubber gloves, and safety goggles. Wear clothes you don't mind discarding or washing immediately afterward. Spores attach to fabric and can be tracked to clean areas of the house.
Step 2: Seal the work area Cover HVAC vents in the room with plastic sheeting and tape. This prevents spores from entering the duct system during cleaning. Keep the door to the rest of the house closed.
Step 3: Apply your cleaning solution For non-porous surfaces (tile, glass, sealed concrete, metal):
- EPA-registered antimicrobial cleaner — follow label instructions for dwell time
- Or: 1 cup household bleach per 1 gallon water — apply, let sit 10–15 minutes
For porous surfaces (drywall, unsealed wood, grout, fabric): Do not clean — remove. Bleach and antimicrobials do not penetrate porous materials deeply enough to eliminate mold at the root level. Cleaning the surface creates the appearance of success while the colony continues growing inside the material.
Step 4: Scrub and wipe Stiff-bristled brush on hard surfaces. Work in sections, moving outward from the center of the affected area. Bag all cleaning materials immediately — don't leave used cloths or brushes in the room.
Step 5: Remove porous materials Drywall, carpet, carpet padding, fiberglass insulation, and soft wood with deep mold penetration need to be cut out and bagged, not cleaned. Double-bag and seal before disposal. The EPA recommends a minimum 12-inch removal margin beyond visible mold growth.
Step 6: Dry completely Run a dehumidifier and fan in the treated area for at least 24–48 hours. Target relative humidity below 50%. Mold cannot sustain active growth below this threshold.
Step 7: Fix the moisture source This is the step most people skip because it's the inconvenient one. A plumbing repair, improved bathroom ventilation, a vapor barrier in the crawl space, or grading around the foundation — whatever is feeding moisture into the space needs to be resolved. Without this step, mold returns in the same location within weeks.
What Official Guidelines Say About Green Mold
The CDC, EPA, and New Jersey Department of Health all address indoor mold with consistent core positions. Here is what they say:
- The EPA recommends that mold growth covering more than 10 square feet be handled by a professional — this threshold applies regardless of mold color or species
- The CDC states that no mold should be tolerated in indoor living spaces and that any visible mold growth warrants investigation of the moisture source
- The EPA's mold remediation guidelines specifically advise that porous materials contaminated with mold should be removed, not cleaned or painted over
- The New Jersey Department of Health advises that building materials wet for more than 48 hours should be treated as presumptively contaminated with mold, regardless of visible evidence
- Both the CDC and EPA note that air quality testing before and after remediation is the only reliable method to confirm that spore levels have returned to acceptable baseline concentrations
- The IICRC S520 Standard — the professional reference for mold remediation — requires negative air pressure containment during removal to prevent cross-contamination to unaffected areas of the building
These positions are consistent across agencies. They are not worst-case scenarios — they represent baseline safe practice guidance.
When to Call a Professional
DIY removal has a defined scope — and crossing its boundaries consistently makes mold problems worse, not better. If any of the following apply, the right call is a professional assessment before you start cleaning anything.
- The affected area is larger than 10 square feet
- Mold has returned after a previous cleaning attempt
- You can smell mold but can't find it — it's growing inside walls, under flooring, or in the HVAC system
- The home experienced water damage, flooding, or a plumbing leak
- A family member has persistent symptoms: chronic cough, unexplained fatigue, recurring respiratory infections
- The home was built before 1980 — disturbing certain building materials without assessment carries asbestos risk
- You have vulnerable household members — children, elderly, immunocompromised, or anyone with asthma

What a professional brings that DIY cannot replicate:
- Thermal imaging — finds moisture pockets inside wall cavities and subfloor assemblies before they become visible
- HEPA containment systems — negative air pressure prevents spores from spreading to clean areas of the home during work
- Post-remediation clearance testing — independent air quality sampling that confirms spore levels have returned to baseline; required by most insurance companies before reconstruction payments are approved
- Certified documentation — necessary for insurance claims and FEMA applications
For a clear breakdown of when DIY stops being appropriate, see our guide on whether you really need a mold specialist.
A Note on Sources and Health Guidance
The health information in this article draws from published positions of the CDC, EPA, and New Jersey Department of Health, as well as peer-reviewed research cited in PubMed. Mold-related health effects vary significantly between individuals — symptoms described here are not diagnostic criteria. If you or a family member are experiencing health symptoms you believe may be related to mold exposure, consult a licensed physician. For structural mold concerns, an IICRC-certified mold remediation professional can assess the scope of the problem and provide appropriate documentation for insurance or medical referral purposes.
Frequently Asked Questions
What is green mold? Green mold is the common name for any fungal growth that produces green-colored spores. In homes, the most frequently identified species are Aspergillus, Penicillium, and Cladosporium — each with different risk profiles, preferred growth surfaces, and removal requirements. Color alone does not identify the species; lab testing is required for confirmation.
Is green mold dangerous? Yes. All green mold species can cause health problems, ranging from allergic reactions and respiratory irritation to mycotoxin exposure in species like Aspergillus and Penicillium. Risk severity depends on the species, exposure duration, and individual health status — particularly for children, the elderly, and immunocompromised individuals.
What causes green mold in a house? Green mold requires three things: moisture, an organic surface, and temperatures above freezing. In homes, it most commonly develops after water damage, in poorly ventilated bathrooms and basements, on damp wood, or in areas with slow plumbing leaks. Resolving the moisture source is the only way to prevent recurrence.
Can green mold make you sick even if I feel fine right now? Yes. Mycotoxin exposure and mold-related sensitization can develop before noticeable symptoms appear. Prolonged low-level exposure — common in homes with hidden mold growth — may lead to cumulative respiratory or immune effects. Some individuals develop sensitivity over time that makes subsequent exposures increasingly symptomatic.
Is green mold worse than black mold? Stachybotrys chartarum (black mold) produces trichothecene mycotoxins that are among the most potent from any indoor mold. However, green molds are not benign — Aspergillus produces aflatoxins classified as carcinogens at high exposure, and Penicillium produces ochratoxin A. The gap in toxicity is smaller than most people assume, and both warrant serious remediation.
How do I get rid of green mold on wood, concrete, or walls? Non-porous surfaces (sealed concrete, tile) can be treated with an EPA-registered antimicrobial or bleach solution with mechanical scrubbing. Porous materials — wood with deep penetration, drywall, concrete block — cannot be effectively decontaminated by surface cleaning. They require physical removal. On any surface, the moisture source must be identified and fixed before or during remediation, or the mold will return.
How do I know if green mold is making me sick? The clearest indicator is symptom improvement when away from the home and worsening when you return. Common signs include persistent cough, nasal congestion, eye irritation, fatigue, and skin reactions. These symptoms overlap with seasonal allergies — professional air quality testing is the only reliable way to determine whether mold is the cause. See our guide on living in a home with mold for more detail on what's safe and what isn't.
Does simple green kill mold? Simple Green's All-Purpose Cleaner is not EPA-registered as a mold disinfectant and is not recommended for mold remediation. For surface mold on non-porous materials, use an EPA-registered antimicrobial product or a bleach-water solution. For porous materials, no cleaning product substitutes for physical removal.
